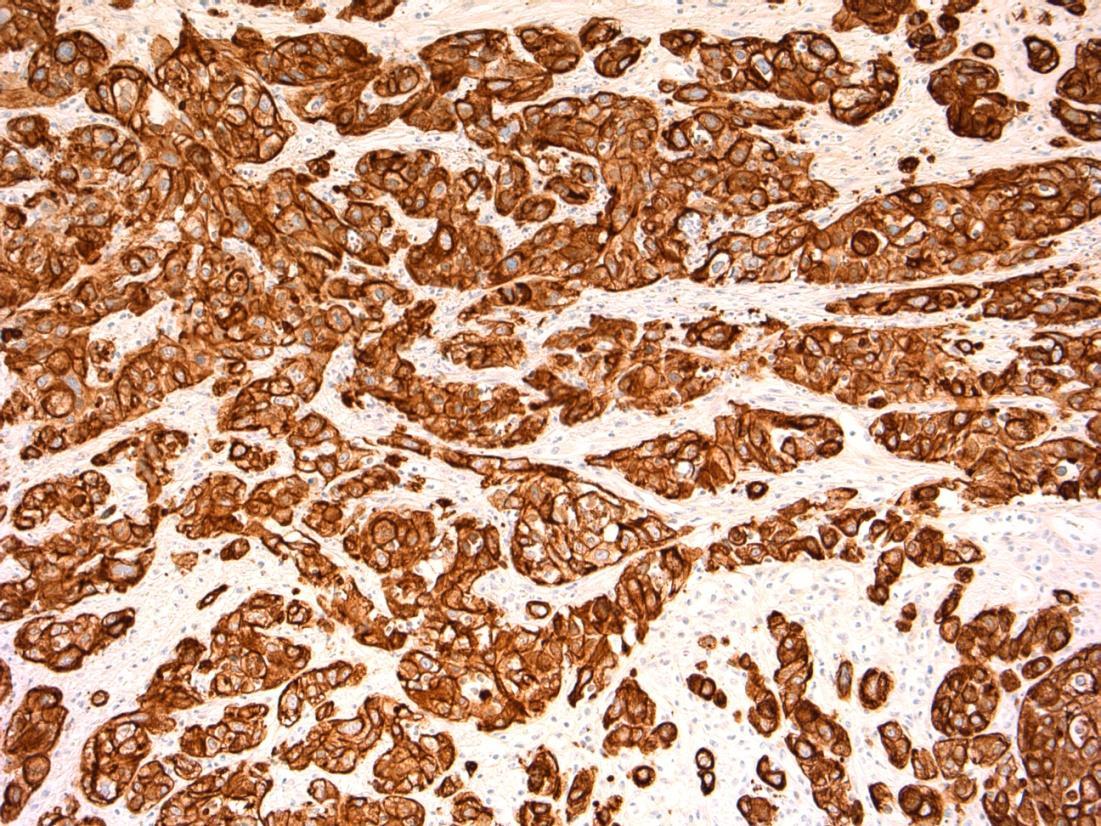
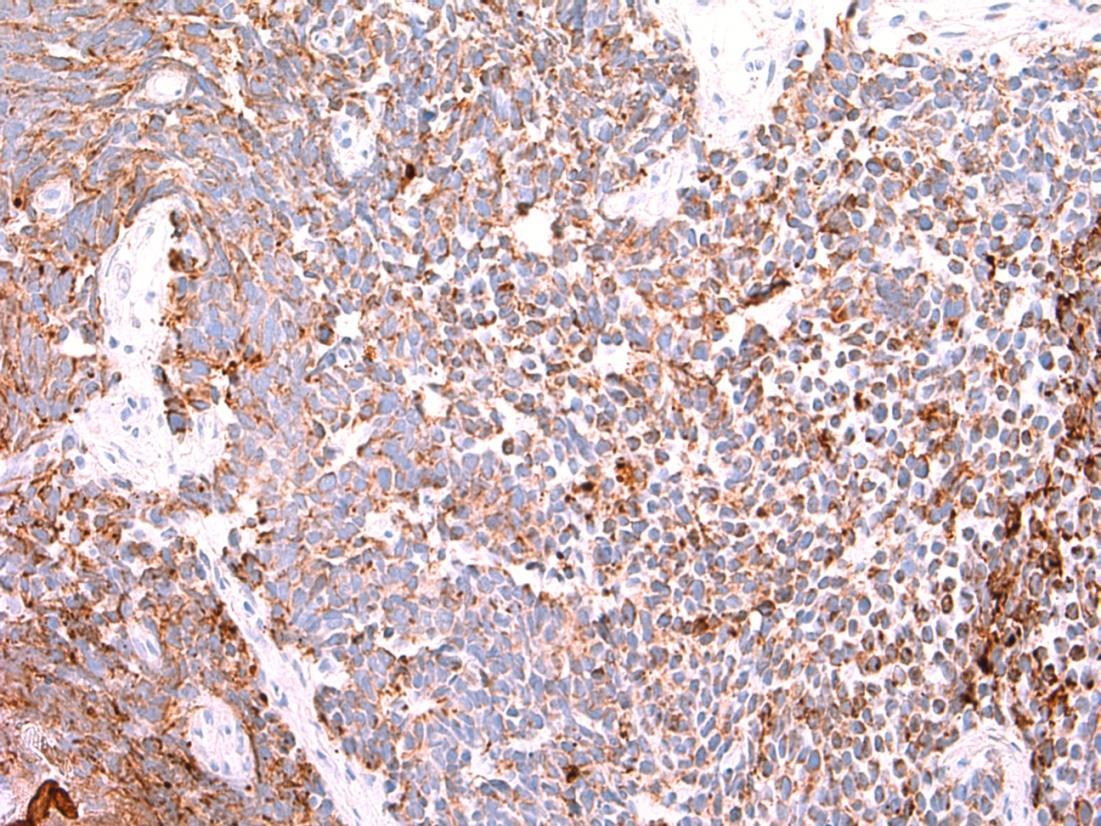
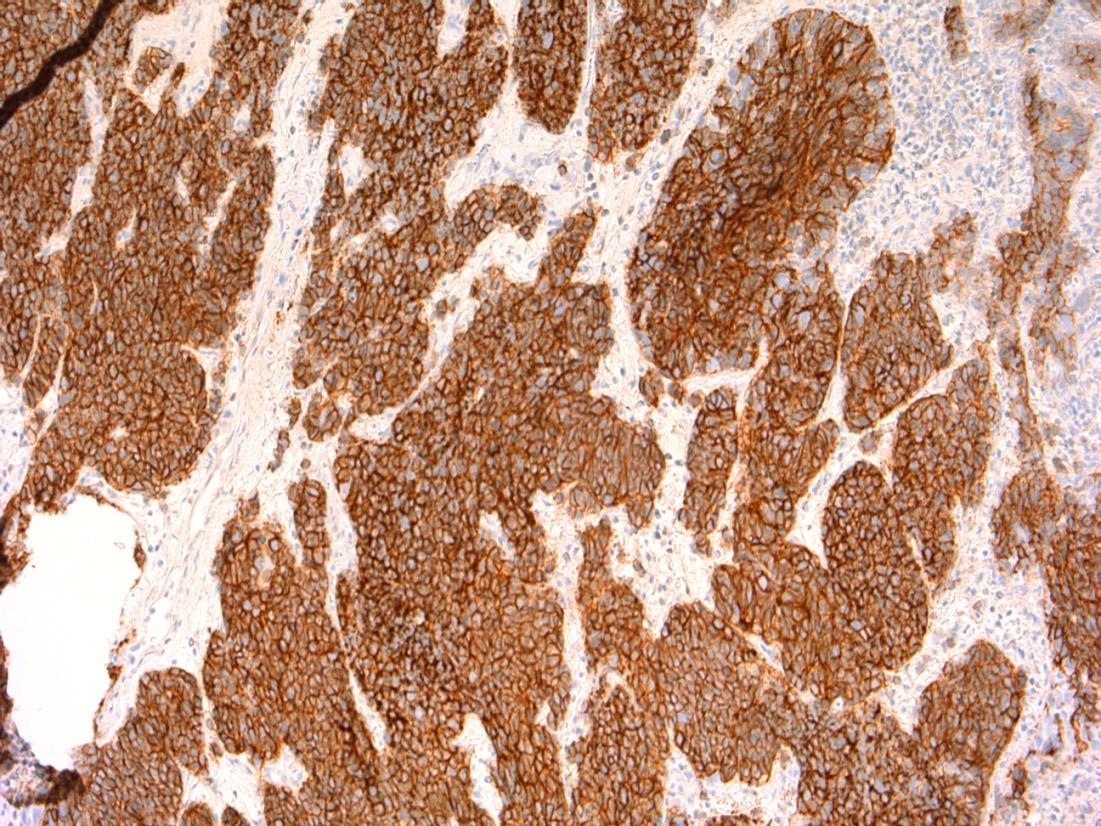
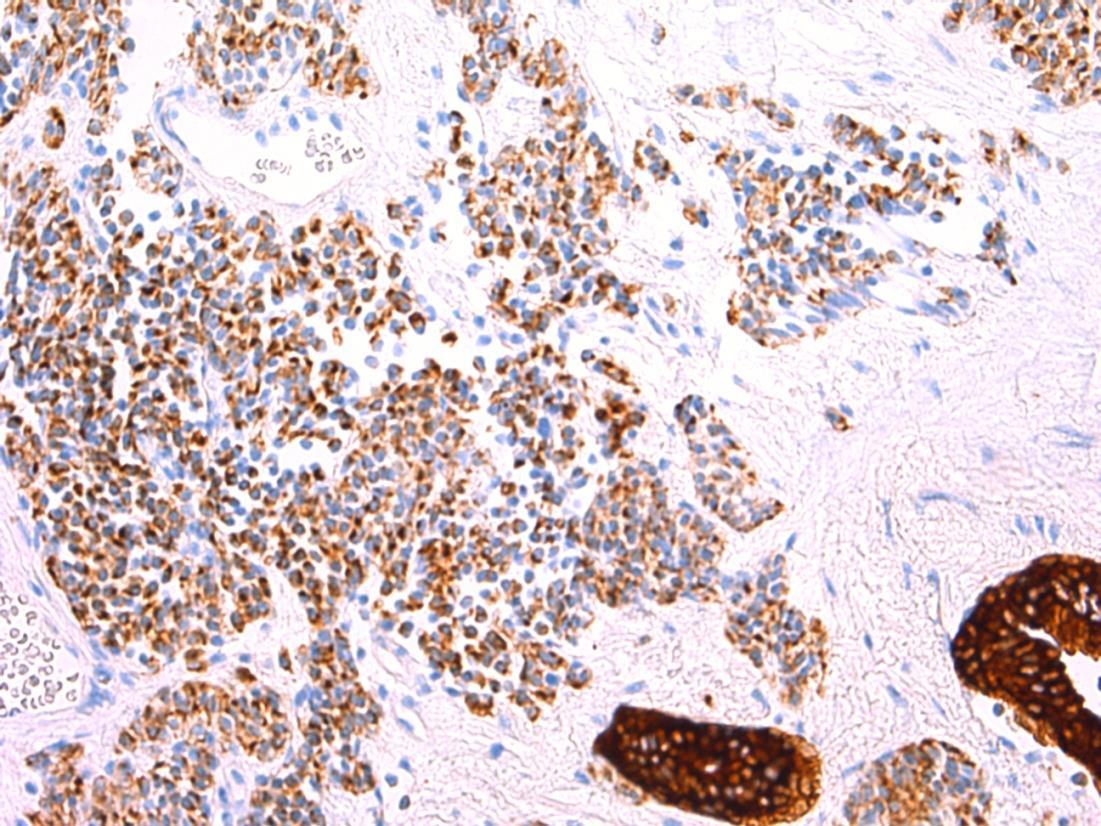
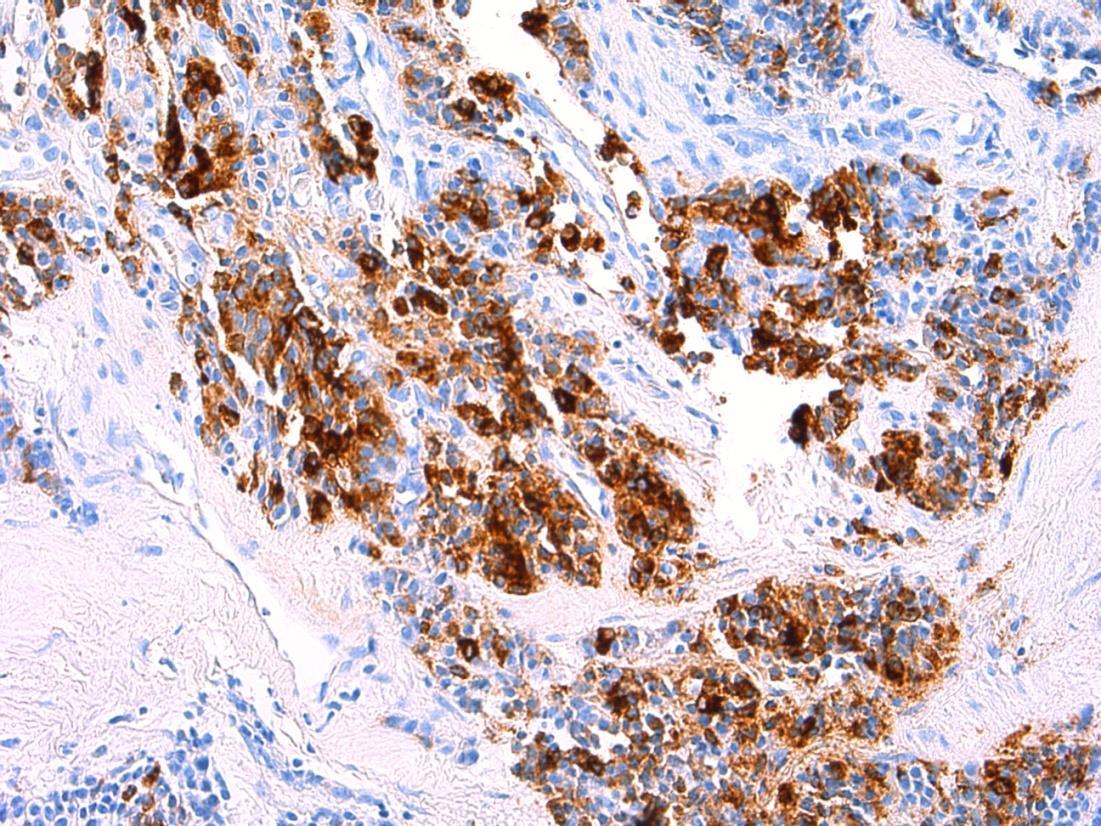
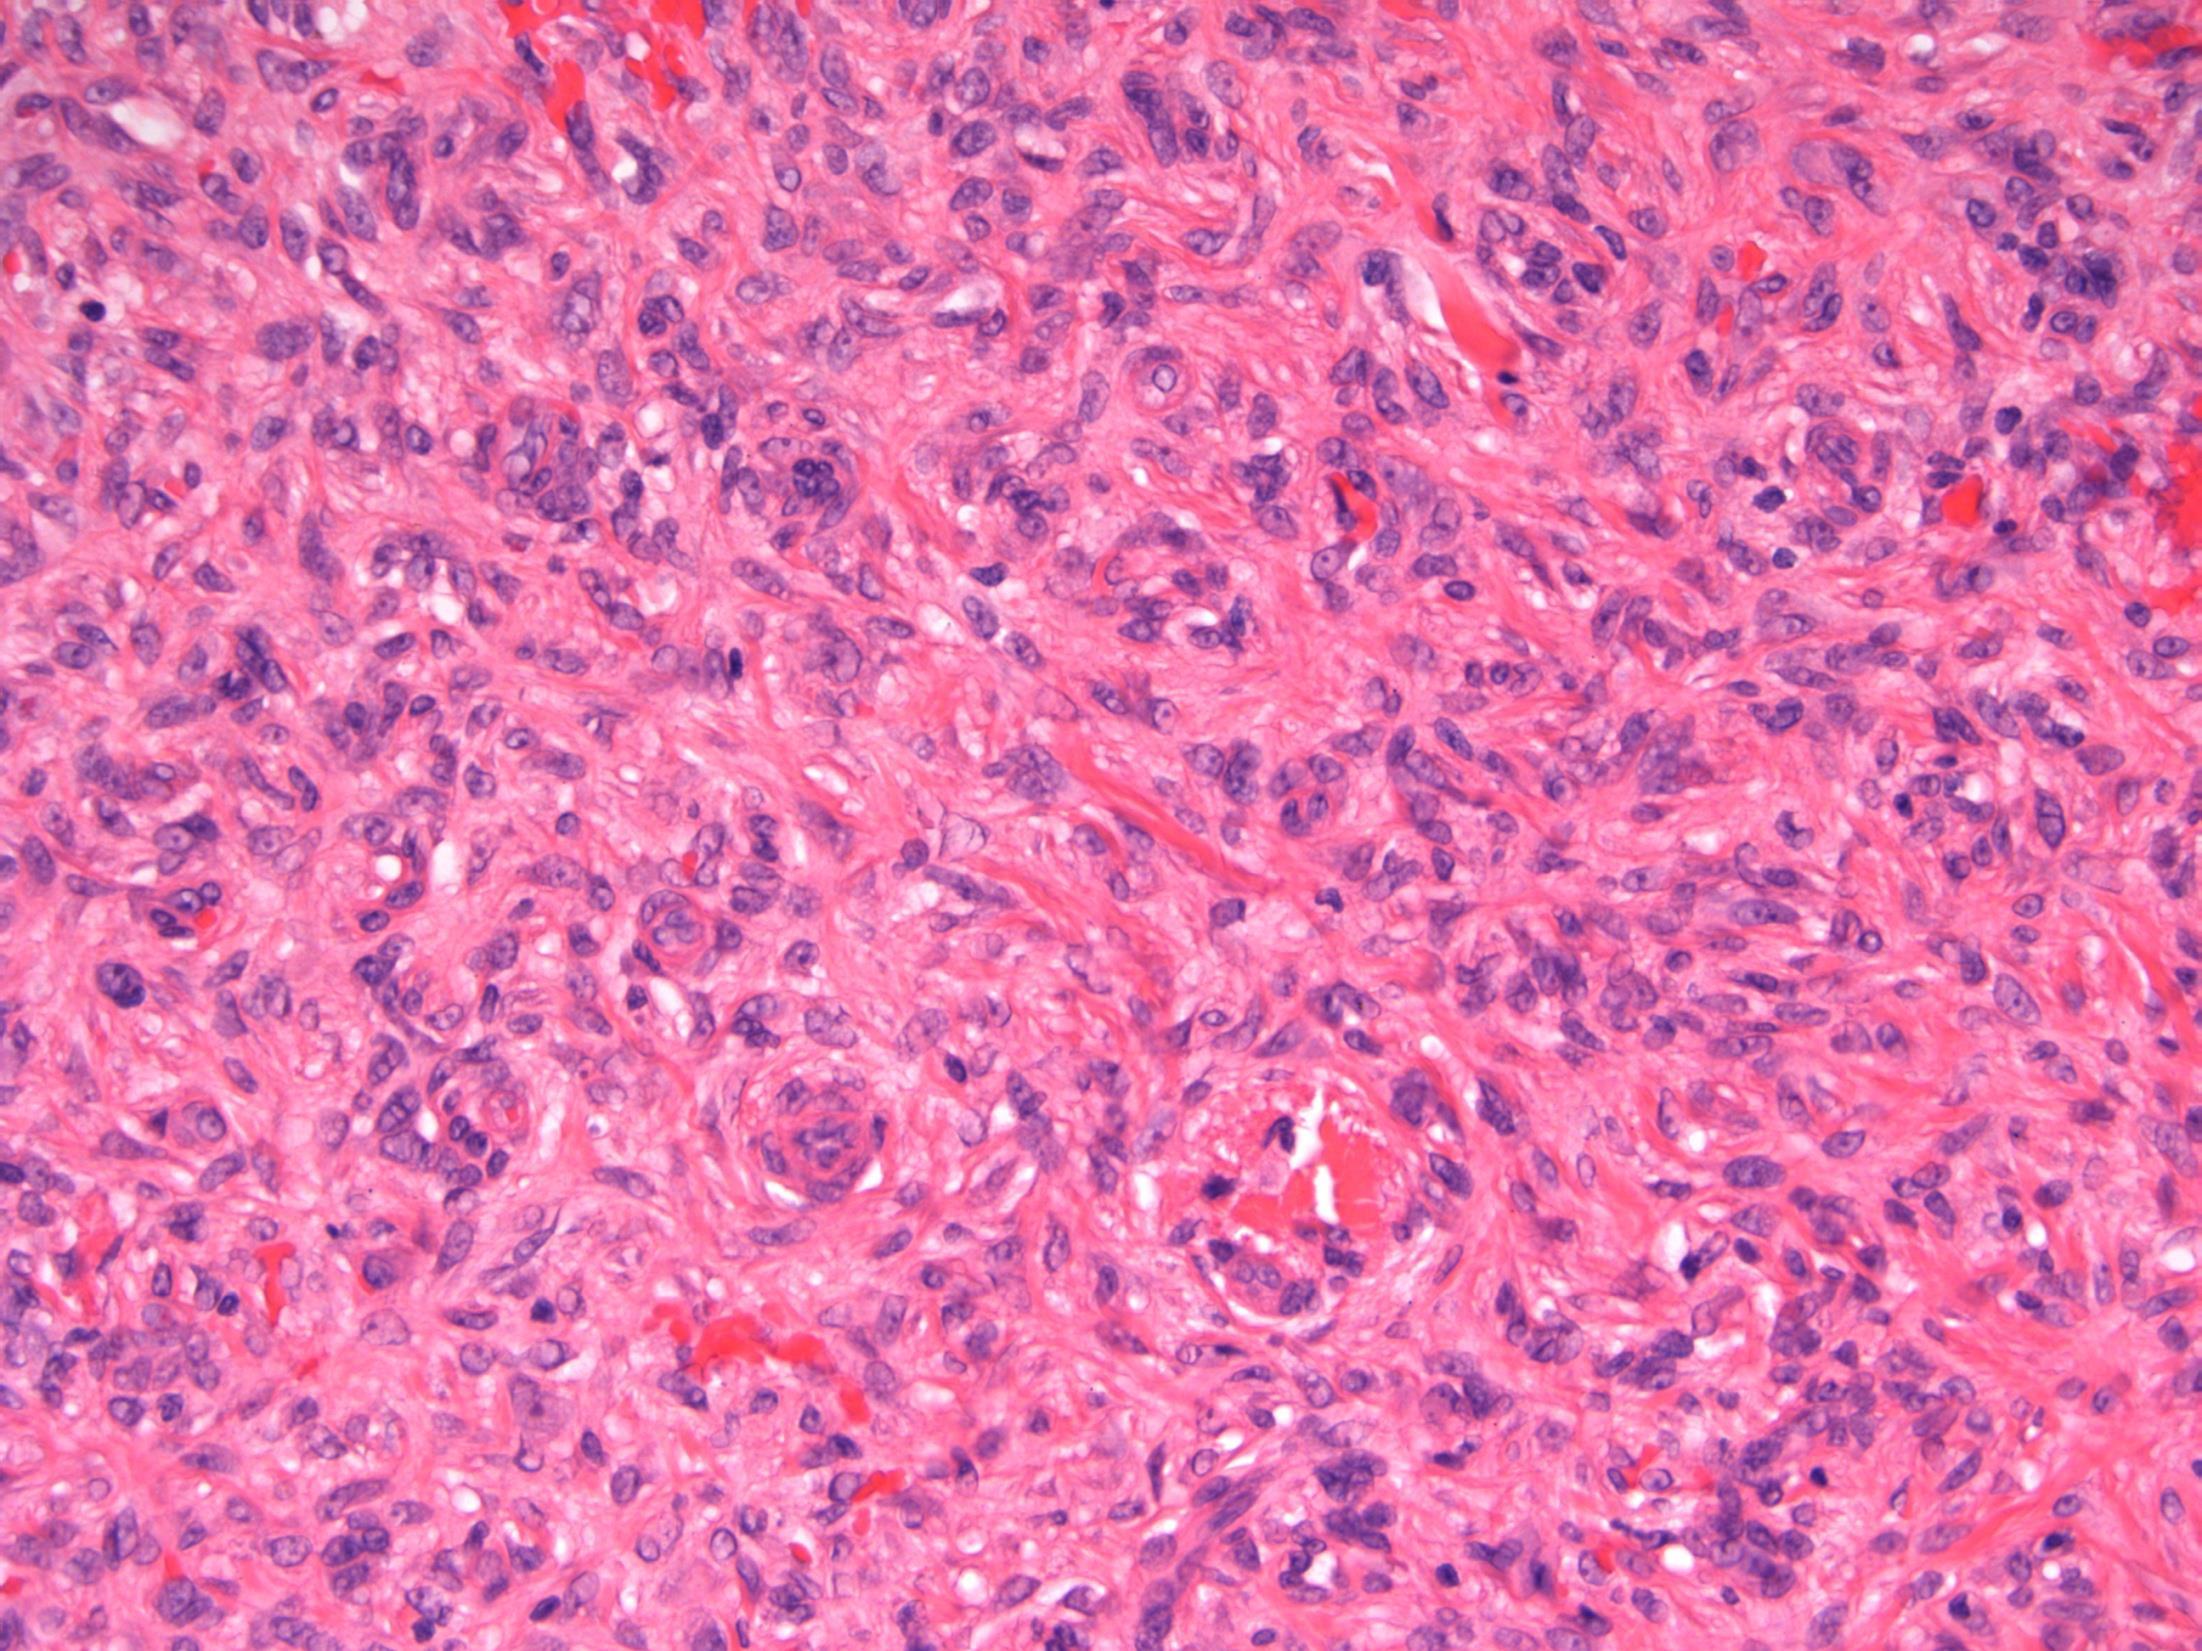

FRCPath mock exam feedback
Dr Sameer Shaktawat Consultant Histopathologist Royal Blackburn Hospital January 2023
Outline of today’s presentation
General tips about the approach to the short cases in the exam (including structure of an answer and the marking scheme)
•
• Discussion of individual cases (1-20) with potential marking scheme for each case

general tips • 20 surgical cases with 10 minutes per case–try not to spend more than 3-4 minutes looking at a slide. Allow 6-7 minutes for writing • Read the history carefully and think about the potential diagnosis for a few seconds before starting. • No one is out to trick you on purpose – your diagnosis should usually fit in neatly with the history, macro (if given), age, sex and site

general tips • Do not feel obliged to give a differential diagnosis on every case – if you are fairly confident about a diagnosis which is not too unusual, follow your instinct & go for it. However, be ‘safe’ if unsure. • Try and imagine yourself reporting on a daily basis (think of: levels, IHC, extra blocks, MDT discussion, referral to colleagues/experts in hard cases)
tips

general
• The
approach is equally important as the correct diagnosis • You need to fight for each and every mark as the system is quite tight with only small allowances for major mistakes – try and excel in the cases you are sure about and minimise damage in cases you are not sure about

general tips • Look at all the past short cases on the Leeds website and the commentary • Don’t worry about learning the TNM staging for all tumours but do have a good idea about the dataset items for common tumours. • Prepare tables for IHC. • Always correlate with the clinical information given in the question.
structure of an answer

1. Description: few lines, focussing on relevant points and descriptive terms. 2. Diagnosis or favoured diagnosis with differential diagnosis in order of preference. 3. Plan: What you will do to refine or confirm your diagnosis and how it will help eg IHC, special stains. Extra things that would be needed for a report eg. Datasets, measurements, mitotic counts, excision, referrals etc. 4. Comments: Relevant clinico-pathological comments. Put as much as you have time for.

structure of an answer • Write as clearly as you can • One answer per page • Headings, paragraphs, tables, underline – try and make your answer a pleasure to read and ‘user-friendly’

marking • Each answer is scored on a scale of 1 to 5 (usually 1.5 to 3.5 is the realistic range) • A score of 2.5/3/3.5 is given for a safe pass A score of 2 is a close fail A score of 1 or 1.5 is a bad fail/’dangerous’ • 4 or more is never awarded! • Should not have > 2 ‘dangerous’ cases • Pass mark > 50
•
Case 1
24F, Intensely itchy, excoriated papulovesicles over knees, left elbow and sacrum. Biopsy from right knee lesion. DIF from adjacent skin: Granular deposits of IgA in dermal papillae.
Case 1
• Skin – Dermatitis herpetiformis




Dermatitis herpetiformis
Description: Acantholytic dermatosis. Subepidermal blisters with neutrophils, oedema in papillary dermis. No evidence of malignancy.
Diagnosis: Dermatitis herpetiformis
Or Favoured Diagnosis : Dermatitis herpetiformis
Differential Diagnosis:
• Linear IgA dermatosis – Children; Similar histology, DIF- IgA linear rather than granular.
• Bullous pemphigoid – Blister lumen and dermis are rich in eosinophils and neutrophils; DIF – linear deposits of IgG, C3 and IgA (40%) at DE junction.
Comments: Autoimmune– IgA against epidermal transglutanimase, association with gluten sensitive enteropathy. Does this patient have any history of coeliac disease?
Typical clinical features -excoriated, grouped papulovesicles on knee, elbow, sacrum, as described in this clinical history. DIF – Granular deposits of IgA in papillary dermis and D-E junction as described for this patient.
3.5 Pathogenesis, associations 3.0 Differential diagnosis and use of DIF 2.5 Description with diagnosis 2.0 Other benign diagnosis with mention of DH 1.5 Other diagnosis with no mention of DH 1.0 Malignant diagnosis
Case 1
2
73M, Headache. CT scan - 4cm mass in sphenoid sinus with focal bone involvement; biopsied
Case
•
• Sphenoid sinus mass - Chordoma
Case
2




Chordoma
Description: lobulated tumour, physaliferous cells with vacuolated cytoplasm, myxoid stroma, considerable variability. Infiltrates bone. Diagnosis : Chordoma Or Favoured Diagnosis: Chordoma Differential diagnosis • Metastatic carcinoma • Clear cell carcinoma (minor salivary gland) • Lipomatous tumour Plan: IHC- chordoma is S100, vimentin, AE1/3, brachyury positive. Difficult case –Needs expert opinion and clinical/radiological correlation. Comments: Commonest in sacral spine (60%), but spheno-occipital/nasal is second commonest site (25%) like in this case. Low - intermediate malignant potential.
3.5 Clinico-pathological features 3.0 Use of IHC, expert review 2.5 Description with differential diagnosis and chordoma favoured diagnosis 2.0 Differential diagnosis with mention of chordoma, but favour other 1.5 Differential diagnosis with no mention of chordoma 1.0 Other definite diagnosis Case 2
Case 3 •
62F, with asthma, recently discharged from hospital after treatment for severe pneumonia. Now has sudden onset bloody diarrhoea and abdominal pain. Biopsy from sigmoid colon.
• Colon – Pseudomembranous coliltis
Case 3



Pseudomembranous colitis
• Description: Patchy necrosis of mucosa, with mushroom shaped fibrinopurulent exudates on surface, crypt withering, hyalinisation of lamina propria
• Diagnosis: Pseudomembranous colitis
Differential diagnosis: Acute ischaemic colitis (can be very difficult – a lot depends on the history and clinical context, but usually more localised / segmental and full thickness necrosis)
• Plan: Correlate with microbiology, antibiotic history, endoscopy etc
• Comments: PMC typically follows antibiotic administration, which correlates well with the history provided. Caused due to toxins of C. difficile
3.5 Pathogenesis, associations 3.0 Points to refine the diagnosis 2.5 Description with diagnosis or differential diagnosis 2.0 Other benign diagnosis but with mention of ischaemic / PM colitis 1.5 Other diagnosis with no mention of ischaemic/PM colitis 1.0 Malignant diagnosis
Case 3
Case
•
4
50F, Breast screening shows a 4mm area of microcalcification in lower outer right breast. Stereotactic core biopsy taken
• Breast cores – Focal lactational change with microcalcifications (B2)
Case 4



Focal lactational change
Description: Dilated acini with secretions, vacuolated cytoplasm and hobnail appearance. Microcalcifications associated. No evidence of DCIS or invasive malignancy.
Diagnosis: Lactational change with microcalcifications (B2)
Plan: Correlate with radiology and clinical examination at the MDT Correlate with any cytology, if perormed.
Comments:
• Biopsied because of microcalcifications .
• Usually seen associated with pregnancy/breast-feeding, unlikley in this age as 50 years old.
• Can be seen in non-pregnant (even nulliparous) women – usually focal, no clinical significance, like in this case.
• Can have associated ADH/DCIS, not present in this case.
• No further treatment required.
3.5 Importance of radiological correlation at MDT 3.0 B coding, significance 2.5 Description with diagnosis / DD 2.0 Other benign diagnosis with no mention of lactational change 1.5 Atypical diagnosis 1.0 Malignant diagnosis Case
4
• 80F, with haematuria. Cystoscopy shows a large tumour on the posterior wall. TURBT performed.
Case 5
•
TURBT - G3 (high-grade) TCC with small cell carcinoma component
Case
5









AE1/3 - TCC AE1/3 – small cell CD56 - TCC CD56 – small cell




–
cell
- TCC
–
P63 - TCC
Synapto
small
Synapto
P63
small cell
G3 (high-grade) TCC with small cell carcinoma component
Description: Biphasic malignant tumour. High grade large epithelial cell component and high grade small round blue cell tumour component. CIS also seen.
Favoured Diagnosis: G3 (high-grade) TCC with small cell carcinoma component. Plan: Correlate with urine cytology/ previous biopsies. IHC: TCC= AE1/3+, p63+, small cell ca = AE1/3 dot +, CD56+, synapto +. Look for invasion into lamina propria and muscle (staging).
Comments: • Small cell carcinoma is frequently admixed with TCC, SCC or adenocarcinoma of bladder • >90% muscle invasive and metastases common, poor prognosis. • Responds to chemotherapy (cisplatin based) • Differential Diagnosis of pure small cell carcinoma: – Poorly-differentiated urothelial carcinoma – Metastatic small cell carcinoma from other site eg lung – Lymphoma – Alveolar rhabdomyosarcoma – Inflammation (in a crushed, cauterised, superficial or scant specimen)
3.5 Associations, prognosis, treatment etc 3.0 Use of IHC for confirmation 2.5 Description with diagnosis, mentions both components 2.0 Only one component mentioned 1.5 Other malignant diagnosis 1.0 Benign diagnosis Case 5
Case
6 • 50M Progressive breathlessness and abnormal liver function tests. Ultrasound shows an abnormal liver texture. Liver biopsy performed.
• Liver biopsy - Cirrhosis with alpha 1 antitrypsin deficiency
Case
6










Cirrhosis with alpha 1 antitrypsin deficiency
Description: Nodules of hepatocytes surrounded by fibrovascular septae. There is ductular reaction and inflammation of varying degrees. Mild steatosis. Also oval cytoplasmic eosinophilic globular inclusions in periportal hepatocytes.
Diagnosis: Cirrhosis with alpha 1 antitrypsin deficiency.
Plan: Liver special stains: A-1 AT – PAS+, diastase resistant, globules in hepatocytes. IHC to A-1AT to confirm.
Correlate with any clinical history of A-1AT lung disease (patient has breathlessness).
Correlate with LFTs, radiology, previous biopsies .
Comments:
PiZZ genotype. Increased risk of HCC
3.5 Clinico-pathological correlation (see clinical history) 3.0 Use of special stains and IHC for confirmation 2.5 Description with diagnosis of cirrhosis + possibility of A1AT deficiency 2.0 Diagnosis of cirrhosis with no mention of A1AT deficiency 1.5 Other non-neoplastic diagnosis with no mention of cirrhosis 1.0 Neoplastic diagnosis Case 6
28F Acute abdominal pain. Laparoscopy showed torted large right ovary, ?Ovarian cyst. Excised. Macro- Ovary measuring 9x8x5cm with a solid and soft cut surface. No cyst seen.
Case
7 •
• Ovary – Massive ovarian oedema
Case
7




Massive ovarian oedema
Description: Diffuse oedema of medulla and inner cortex; relative sparing of outer cortex. Associated RBC extravasation, congestion, inflammation. No cyst seen. No evidence of malignancy.
Diagnosis: Massive ovarian oedema
Differential Diagnosis:
• Fibroma/ fibrothecoma. May show marked oedema but tumour usually replaces entire ovary with no sparing at edges.
• Krukenberg tumour. Can look similar macroscopically and malignant cells can be sparse. Usually older females but can occur in younger females.
Plan:
• Extra blocks to exclude sparse tumour cells.
• Correlate with radiology.
Comments:
Partial torsion of an otherwise normal ovary.
Common in 2nd and 3rd decade – like this case.
Macroscopically a featureless myxoid enlarged ovary (correlates with macro features).
3.5 Cause, prognosis, treatment etc 3.0 Differential diagnostic considerations 2.5 Description with diagnosis 2.0 Other benign diagnosis with no consideration of ovarian oedema 1.5 Differential diagnosis, favouring malignant 1.0 Definite malignant diagnosis Case 7
• 38M, Smoker, c/o haemoptysis. 3cm tumour in left main bronchus biopsied
Case
8
• Bronchus – typical carcinoid
Case 8







AE1/3 chromogranin
CD56 TTF-1
Typical carcinoid
Description: Nests and islands of monomorphic cells, uniform central nuclei, eosinophilic cytoplasm. <2 mitoses/ 2mm square. No necrosis. No marked atypia.
Diagnosis: Typical carcinoid.
Differential diagnosis: Atypical carcinoid ( >2 mitoses/2mm and/or necrosis, can show nuclear atypia)
Plan: Check levels for focal necrosis/ atypia/mitoses
Correlate with radiology - tend to be well-circumscribed.
IHC - Would stain positive for AE1/3(dot+), CD56, chromogranin, TTF-1
Comments
• Not smoking associated • Indolent growth, metastases rare at diagnosis
• Usually age < 40 years old, like in this patient (age 38).
3.5 Associations, prognosis, treatment etc 3.0 Use of IHC for confirmation, differentiation from atypical carcinoid 2.5 Description with diagnosis 2.0 DD including but not favouring typical carcinoid 1.5 DD favouring a malignant diagnosis and no consideration of typical carcinoid 1.0 Definite malignant diagnosis Case 8
9
27F, Irregular PV bleeding for the past 5 months. Endometrial pipelle biopsy.
Case
•
9
Endometrial pipelle - Proliferative endometrium with old placental site / placental site nodule
Case
•






Placental site nodule
Description: Fragments of endometrial tissue containing proliferative phase glands. In addition there are well-circumscribed hyalinised nodules containing epithelioid trophoblastic cells. No evidence of malignancy.
Diagnosis: Proliferative endometrium with old placental site / placental site nodule
Differential Diagnosis: Placental site trophoblastic tumour (larger, not well circumscribed, less hyalinization, mitotically active, weak staining for PLAP)
Plan: IHC: Trophoblast is AE1/3, p63, PLAP, inhibin +ve, hcg -ve
Correlate with history of a previous pregnancy.
Comments:
Previous gestation that fails to involute. May be identified many years after pregnancy. Often an incidental finding on endometrial biopsies.
3.5 Clinico-pathological correlation 3.0 Potential use of IHC for confirmation of trophoblastic cells 2.5 Description with diagnosis 2.0 Other benign diagnosis 1.5 Favouring some neoplastic process 1.0 Definite malignant diagnosis
Case 9
Case
•
10
42F, Clinically symptomatic colloid goitre. Total thyroidectomy performed. No pre-operative FNA performed. Grossly, no focal lesions seen.
Thyroid – Florid Hashimoto’s thyroiditis
Case
10 •





Hashimotos thyroiditis
Description: Extensive lymphocytic infiltrate with germinal centre formation. Plasma cells seen. Atrophic follicles with Hürthle cells. Reduced colloid. Some cleared nuclei but no well-defined nodule.
Diagnosis: Hashimoto’s thyroiditis
Plan:
• Check extra blocks for co-existing PTC or MZL.
• Correlate with history and macro (symmetrical enlargement of both lobes).
• Correlate with autoantibodies, eg TSH.
Comments:
Hashimoto’s thyroiditis
• Almost always in females, usually age 40-50- like in this case.
• Associated with SLE, rheumatoid arthritis, Sjögren syndrome, pernicious anaemia
• Differential Diagnosis:
– Papillary carcinoma – Nuclei in HT often show nuclear clearing, enlargement, overlapping (reactive changes). A well-defined separate nodule should be seen before diagnosing Ca
–
In a background of HT, areas with a more diffuse, monotonous proliferation of small lymphoid cells with clear cytoplasm; lymphoepithelial lesions and destruction of native follicles
MZL –
3.5 Clinico-pathological correlation 3.0 Differentiation from potential mimics (papillary Ca, MALT lymphoma) 2.5 Description with diagnosis 2.0 Other benign diagnosis 1.5 Favouring or suspicion of a neoplastic process 1.0 Definite malignant diagnosis Case 10
11
43M Slowly growing lump on the 4th toe of right foot measuring 2.5cm, excised
? Neoplasm
Case
•
• Excision toe – Fungal mycetoma
Case 11




Mycetoma
Description: Inflamed/granulation tissue/abcess with
No evidence of
Plan: Special stains- Grocott/silver stain, PAS. Correlate with microbiology, radiology. Comments: • Uncommon chronic infective condition of S/C tissue – triad of tumefaction, draining sinuses and colonial grains • 2 causes – fungal or Actinomyces – Correct
the agent is necessary as it guides the mode of treatment.
grains of fungal hyphae.
malignancy.
identification of
3.5 Pathogenesis, treatment etc 3.0 Importance of differential diagnosis (fungal vs actinomyces) 2.5 Description with diagnosis (fungal infection) 2.0 Other benign diagnosis with mention of fungal 1.5 Other diagnosis with no mention of fungal 1.0 Neoplastic diagnosis
Case 11
Case 12 • 41F with a breast implant. Mammogram showed multifocal microcalcifications. Initial core biopsy B1, repeat core biopsy B5a. Mastectomy performed – section from this specimen.
• Breast – High grade DCIS + displaced epithelium + silicone granuloma
Case 12








Description: Breast tissue showing areas of high grade DCIS of flat/micropapillary type. Also areas of foamy macrophages with giant cells. Focally can see a fibrous tract containing small groups of bland epithelial cells. No evidence of invasive malignancy.
seen following previous needling –
–
–
Diagnosis: High grade DCIS + displaced epithelium + silicone granuloma Plan: Correlate with clinical findings, radiology, previous biopsy (B5a) and cytology. Check other blocks for invasive malignancy. Measure distance to margins. Breast MDT discussion. Comments: Epithelial displacement
Small and dispersed clusters of epithelial cells seen within the fibroblastic reactive stroma
Can simulate malignancy
p63 and SMM – negative Silicone granuloma associated with breast implants (as in this case).
3.5 Mention of epithelial displacement and justification 3.0 Clinico-pathological correlation of all features 2.5 Description with diagnosis (DCIS, silicone granuloma) 2.0 DCIS only; No mention of silicone granuloma 1.5 Suspicious of invasive carcinoma 1.0 Invasive carcinoma; benign diagnosis Case 12
•
45M 2cm lump in tail of the epididymis excised
Case 13
Epididymis – Adenomatoid tumour
Case 13 •




tumour Description: Well cirumscribed tumour with glandular/vascular type structures with vacuolated cytoplasm within fibro-muscular stroma, reactive lymphoid aggregates at periphery. No mitoses, no necrosis. Diagnosis: Adenomatoid tumour Plan: IHC: mesothelial markers calretinin+ AE1/3+ Comments: • Most common paratesticular neoplasm, including epididymis, like in this case • Mesothelial in origin; benign • Wide spectrum of growth patterns – tubular, solid, cystic, angiomatoid • Differential Diagnosis : – Adenocarcinoma (BerEp4/ MOC31+) – Malignant mesothelioma (necrosis/ mitoses/ more infiltrative)
Adenomatoid
3.5 Clinical features 3.0 Differential diagnosis and use of IHC 2.5 Description with diagnosis 2.0 Differential diagnosis with consideration of adenomatoid tumour 1.5 Favour other diagnosis with no mention of adenomatoid tumour 1.0 Malignant diagnosis
13
Case
64F. Incidental imaging finding of nodule measuring 4cm in segment 2 of liver ? HCC.
Liver lobe resection received.
Case
14 •
Liver - angiomyolipoma
14
Case
•







HMB45 CD117 AE1/3 SMA
Liver Description: Liver containing well circumscribed spindle cell tumour with 3 components – smooth muscle cells (predominant), adipose tissue and blood vessels. Diagnosis: angiomyolipoma Differential Diagnosis: Leiomyoma (usually no prominent vascular or adipose component, negative for HMB45) GIST (CD117+) Mets of sarcoma / spindle cell carcinoma – more atypia Plan: IHC: SMA+, HMB45+, CD117-, AE1/3+ Correlate with clinical history ? Tuberous sclerosis etc Comments: • Liver is 2nd commonest site after kidney • Often detected incidentally, usually benign • May be sporadic but is associated with tuberous
and with TSC2 / PKD1 contiguous gene
(especially if
AML
sclerosis
syndrome
bilateral/multifocal).
3.5 Clinical features, associations 3.0 Differential diagnosis and use of IHC 2.5 Description with diagnosis or DD including AML 2.0 Differential diagnosis with mention of AML but favouring other diagnosis 1.5 Differential diagnosis with no mention of AML or a benign diagnosis 1.0 Malignant diagnosis Case 14
15 • 43M 3cm mass in hypopharyx. Biopsy from mass received as multiple tan fragments
Case
Case 15 •
Hypopharynx – Adult rhabdomyoma


desmin




S100 PAS PAS - D
Masson’s trichrome

Adult rhabdomyoma
Description: Sheets of large polygonal cells with eccentric nuclei and abundant granular eosinophilic or vacuolated cytoplasm.
Diagnosis: Adult Rhabdomyoma
Differential Diagnosis:
• Granular cell tumour- pseudoepitheliomatous hyperplasia, S100+
• Oncocytoma – usually parotid / sm gland, AE1/3+
• Paraganglioma – organoid nests (‘zellballen’), NE markers +
Plan: IHC (see above): Rhabdomyoma is desmin+ myogenin+
Comments:
Benign tumour of mature skeletal muscle
90% of extracardiac RMs occur in head and neck (oral cavity, pharynx, larynx)- like in this case.
Can recur locally but lack local aggressiveness and malignant potential
3.5 Clinico-pathological correlation 3.0 Differential diagnosis and use of IHC 2.5 Description with diagnosis or DD favouring rhabdomyoma 2.0 Differential diagnosis with mention of rhabdomyoma 1.5 Other diagnosis (eg granular cell t) with no mention of rhabdomyoma 1.0 Malignant diagnosis Case 15
71F. Abdominal pain and diarrhoea. Upper GI endoscopy normal. D2 biopsy taken to exclude coeliac disease
Case
16 •
•
Duodenum - Giardiasis
Case 16



Giardiasis
Description: Small bowel mucosa of normal architecture. Trophozoites along the surface of epithelial cells. The organisms are teardrop/pear/comma shaped with paired nuclei. No evidence of malignancy. No evidence of coeliac disease.
Diagnosis: Giardiasis.
Plan: Correlate with clinical/travel history
Comments:
Protozoan infection associated with malabsorption and chronic diarrhoea (this lady had diarrhoea).
Spreads by faecally contaminated water, usually underdeveloped countries ( hence travel history important).
3.5 Clinical features and associations 3.0 Justification of diagnosis; exclude coeliac disease 2.5 Description with diagnosis 2.0 Other non-neoplastic diagnosis with mention of giardia 1.5 Other non-neoplastic diagnosis with no mention of giardia 1.0 Neoplastic diagnosis
16
Case
61M. Pigmented lesion excised from right forearm
Case
17 •
• Skin - dermatofibroma
Case 17






Dermatofibroma
Description: Pseudoepitheliomatous hyperplasia of the overlying epidermis. In dermis –short fascicles of spindle cells with individual collagen bundles surrounded by lesional cells at the periphery; giant cells, macrophages, inflammatory cells. Focal extension to subcutis.
Diagnosis: dermatofibroma
Plan: Correlate with clinical history: Often appear after a minor injury to the skin, vaccination or insect bite. Check other blocks for excision status.
Comments:
Many variants (aneurysmal, cellular, atypical)
Benign behaviour
Extremities commonly affected – like in this case. Local recurrence is rare, even with involved margins
3.5 Behaviour; correlation with history 3.0 Justification of diagnosis and exclude other malignant diagnosis (?IHC) 2.5 Description with diagnosis 2.0 Other benign diagnosis with mention of dermatofibroma 1.5 Other diagnosis with no mention of dermatofibroma 1.0 Malignant diagnosis
17
Case
18
90F. Lump in tongue excised.
Case
•
Diagnosis
• Tongue - Amyloidosis




CONGO RED

Description: Normal mucosa. Stroma contains paucicellualr amorphous eosinophilic material. Also seen around blood vessels. No evidence of dysplasia or malignancy. Diagnosis: Amyloidosis Plan: • Congo Red- stains deep pink and demonstrates apple green birefringence • Send to National amyloid centre – prove amyloid and type. • Correlate with clinical history for type eg myeloma, RhA etc Comments: • Can be primary (‘amyloidoma’) or secondary (eg multiple myeloma) • Multiple types of amyloid • Older patients
Tongue amyloid
3.5 Clinico-pathological correlation (primary vs secondary amyloid) 3.0 Differential diagnosis and use of special stains 2.5 Description with diagnosis 2.0 Other benign diagnosis with mention of amyloid 1.5 Other benign diagnosis with no mention of amyloid 1.0 Malignant diagnosis Case 18
82M. Partial maxillectomy for a 3cm keratotic growth. Two previous biopsies were nonconclusive.
Case 19 •
• Maxilla – Verrucous carcinoma
Case 19


Verrucous carcinoma
•
Description: Abrupt transition between tumour and epithelium. Plump papillary invaginations of thickened and infolding epithelium, hyperkeratosis. Lack of cytological atypia, suprabasal mitoses. Retraction of normal epithelium at margin. Diagnosis: Verrucous carcinoma Differential Diagnosis:
Conventional SCC – cellular atypia • Squamous papilloma – more exophtyic & branching, less keratin • Reactive inflammatory epithelial hyperplasia – most difficult but rete pegs more slender and anastomosing; no mitoses; macro correlation Plan: Correlate with previous biopsies ( often quite bland so can be inconlusive) Examine further blocks for worse areas and measure margins. Comments: In head and neck – oral cavity and larynx Often large, locally aggressive, pushing margin Better prognosis than SCC
3.5 Clinical features 3.0 Potential differential diagnosis with justification (correlate history too) 2.5 Description with diagnosis 2.0 Differential diagnosis with mention of verrucous carcinoma 1.5 Uncertain, but some mention of ‘atypia’ 1.0 Benign diagnosis Case 19
20
60F. Diarrhoea. Biopsy from caecum.
Colonoscopy was normal
Case
•
• Colon – Collagenous colitis
Case
20



Collagenous colitis
Description: Large bowel mucosa with subepithelial collagen deposition, surface epithelial detachment. More inflammatory cells in lamina propria. No dysplasia or malignancy. Diagnosis: collagenous colitis Plan: Confirm with Masson’s trichrome. Comments: • Chronic watery diarrhoea, normal endoscopy- as in this case • May represent similar entity as lymphocytic colitis- spectrum of disease. • F:M 6-8:1; Often associated disease – RA, DM, thyroid disorder, coeliac disease
3.5 Clinical features, associations 3.0 Special stains for confirmation; any differential? 2.5 Description with diagnosis 2.0 Other non-neoplastic diagnosis with mention of collagenous colitis 1.5 Other non-neoplastic diagnosis with no mention of collagenous colitis 1.0 Neoplastic diagnosis Case 20

THANK YOU AND BEST OF LUCK!!